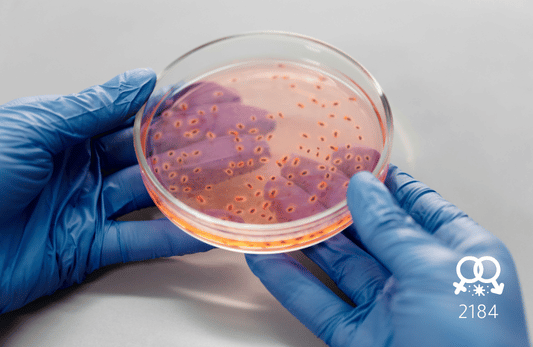
الكلاميديا ​​(IgG)

تفاصيل التحليل
تحليل أجسام مضادة للكلاميديا (Chlamydia IgG)
تحليل مخبري للكشف عن الأجسام المضادة (IgG) لبكتيريا الكلاميديا لتحديد الإصابات السابقة أو المزمنة وحماية الصحة الإنجابية من أي مخاطر.
الصورة التوضيحية المرتبطة بهذا التحليل